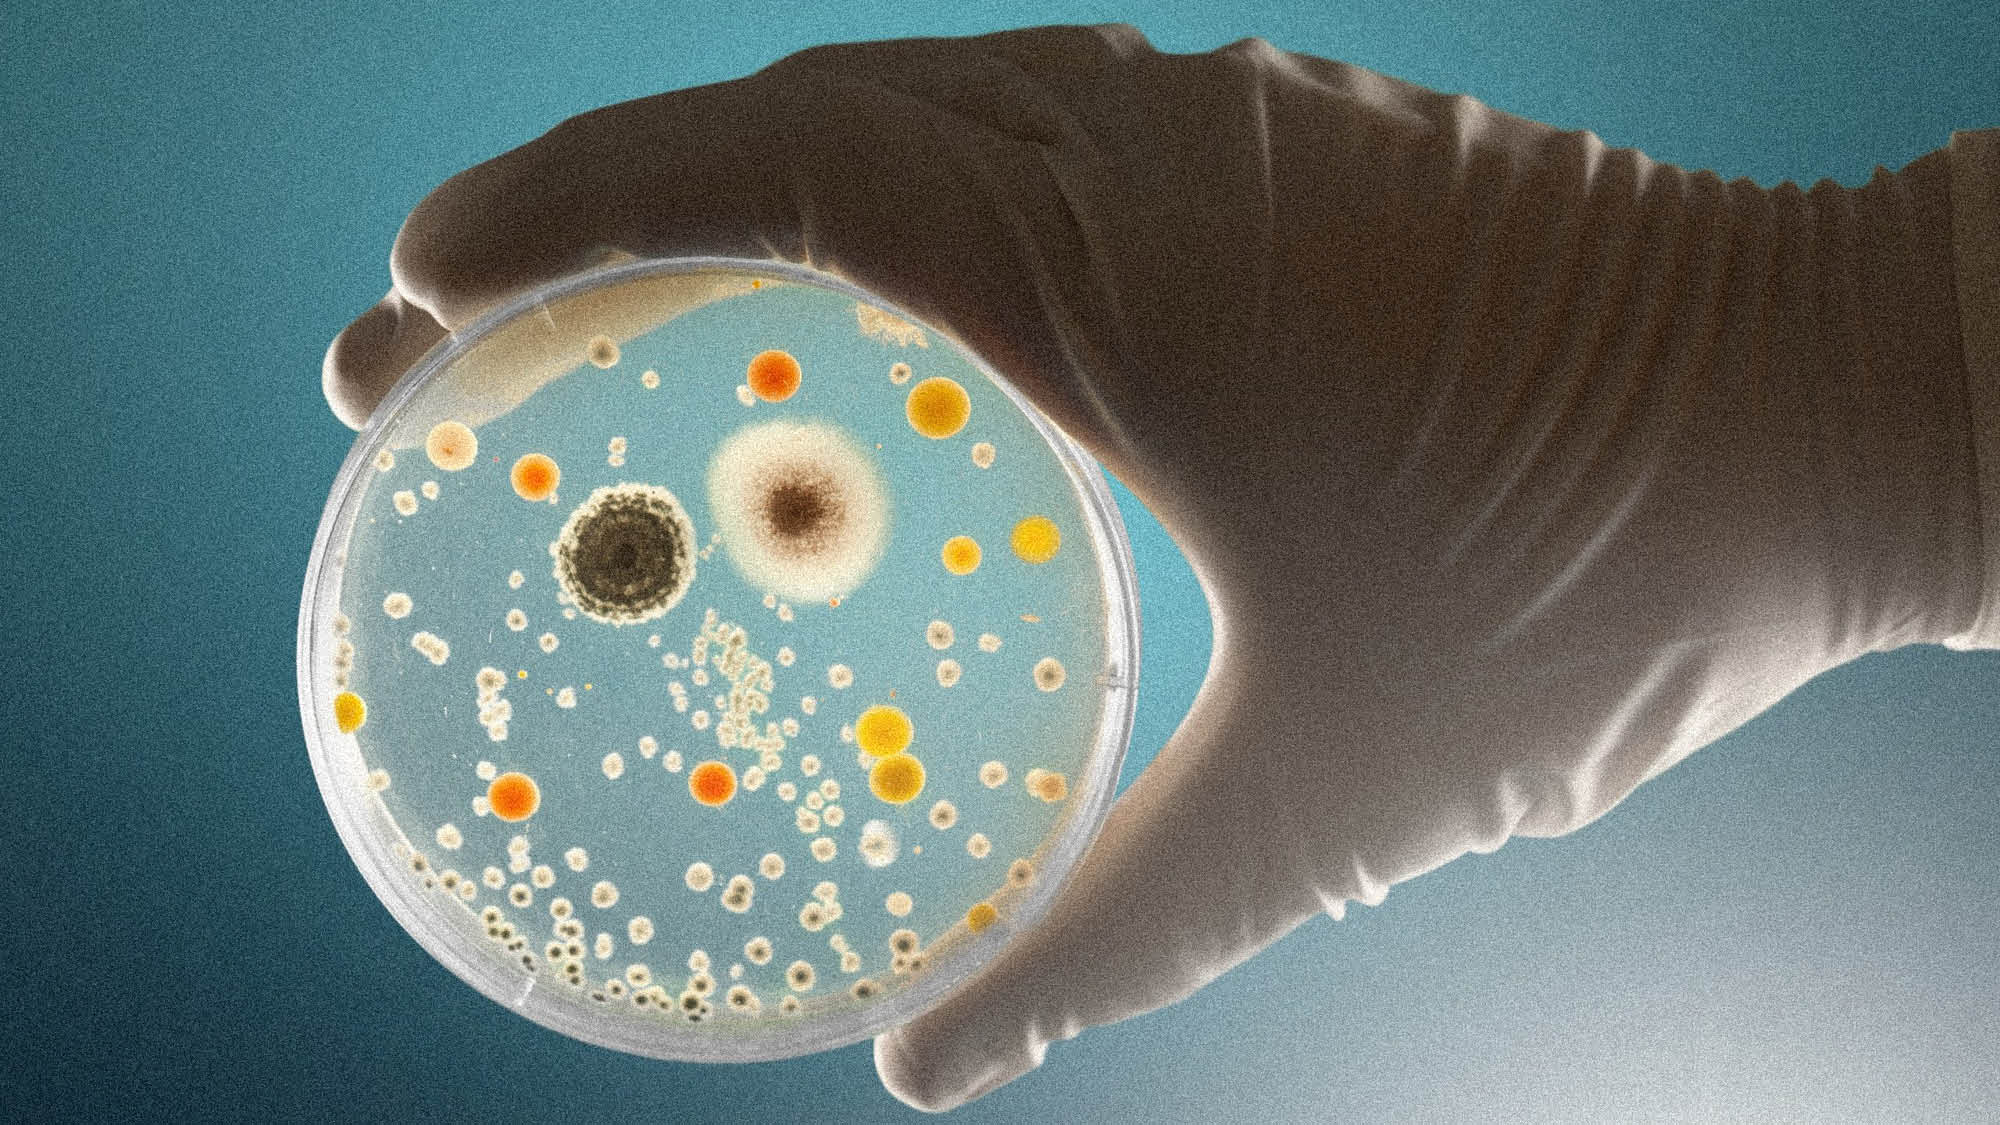

MedTech Europe
Brand Strategy - Brand Design
Création - Transformation - Regroupement
Type de mission : Alignement culturel & Repositionnement d’identité dans le cadre d’une fusion
Secteur : Industrie des technologies médicales (association européenne)
Brand Strategy - Brand Design
Création - Transformation - Regroupement
Type de mission : Alignement culturel & Repositionnement d’identité dans le cadre d’une fusion
Secteur : Industrie des technologies médicales (association européenne)

Brand Strategy
01/
Défi
Deux organisations historiquement différentes (EDMA et Eucomed) devaient fusionner en une seule association. Le risque : une identité artificielle, non partagée, incapable de fédérer des cultures opposées et de clarifier le rôle du nouvel ensemble auprès des membres et parties prenantes.
02/
Solution
L’analyse des identités culturelles a révélé deux forces complémentaires : EDMA : rigueur, discipline, expertise scientifique, ancrage profond, Eucomed : ouverture, innovation, diversité technologique, ambition. Ce contraste, longtemps perçu comme une incompatibilité, formait en réalité une dynamique idéale. Précision + exploration. Cette complémentarité permettait de couvrir l’ensemble du continuum de soins et de créer une valeur nouvelle impossible à atteindre séparément.
03/
Impact
La nouvelle identité commune a été adoptée à l’unanimité par le Board. Le positionnement unifié a permis : Une compréhension claire du rôle de la nouvelle association, une communication interne et externe plus cohérente, une mobilisation culturelle facilitant l’intégration des équipes et des membres. Cette base identitaire a servi de fondation pour le développement d’un système visuel, d’un discours stratégique et d’un écosystème de communication aligné sur la vocation réelle de MedTech Europe.
